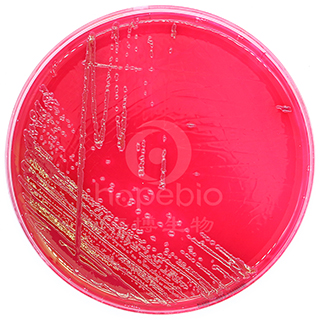
产品细节图片2

万千商家帮你免费找货
0 人在求购买到急需产品
- 详细信息
- 文献和实验
- 技术资料
- 保存条件:
请置于阴凉干燥处保存
- 保质期:
3个月
- 英文名:
Fuchsin Basic Sodium Sulfide Agar Plate
- 库存:
100
- 供应商:
青岛海博生物
- 规格:
10个/包
用途:用于饮用水、水源水中总大肠菌群的选择性分离和确证。
检验原理: 蛋白胨、酵母粉、牛肉粉提供碳氮源、维生素和矿物质;乳糖为可发酵的糖类;琼脂是培养基的凝固剂;磷酸氢二钾为缓冲剂;亚硫酸钠能将碱性品红还原,使其褪色。乳糖发酵的细菌产生乙醛,在存在碱性品红的情况下乙醛与亚硫酸钠结合形成红色菌落,快速发酵乳糖的细菌产生金属光泽,不发酵乳糖的细菌形成无色透明菌落。
品红亚硫酸钠琼脂培养基的原理及使用注意事项:http://www.hopebiol.com/asphtml/refere9463.htm
|
|
|
| 品红亚硫酸钠琼脂 大肠埃希氏菌ATCC25922 |
品红亚硫酸钠琼脂 弗氏柠檬酸杆菌ATCC43864 |
|
|
|
| 品红亚硫酸钠琼脂 鼠伤寒沙门氏菌ATCC14028 |
|
接种以下质控菌株,放置36±1℃需氧培养24±2小时。

风险提示:丁香通仅作为第三方平台,为商家信息发布提供平台空间。用户咨询产品时请注意保护个人信息及财产安全,合理判断,谨慎选购商品,商家和用户对交易行为负责。对于医疗器械类产品,请先查证核实企业经营资质和医疗器械产品注册证情况。
 文献和实验
文献和实验标签。 3.实验所需药口及配制 浓盐酸(36—38%),碱性品红,偏重亚硫酸钠(Na 2 S 2 O 5 ); 亚硫酸钠(Na 2 SO 3 ),固绿(fast green),加拿大中性树胶乙醇(30—100%),二甲苯。 药品配制: 1各种浓度的乙醇配制. 21NHCI配制:取浓HCI 82.5毫升加蒸馏水至1000毫升,摇匀。 3Sciff 试剂的配制
DNA的细胞化学:孚尔根反应(Feulgen Reaction)
验 原 理 自Feulgen等发明该显示DNA的Feulgen反应法以来,其作用机制也久经研究和讨论,现已取得一致意见。其具体反应原理是,标本经稀盐酸水解后,DNA分子中的嘌呤碱基被解离,从而在核糖的一端出现了醛基。Schiff 试剂 中的无色品红可与醛基反应,形成含有醌基的化合物分子, 因醌基为发色团,故可呈现出紫红色。也就是说, DNA经稀酸水解后产生的醛基,具有还原作用,可与无色品红结合形成紫红色化合物,从而显示出DNA的分布。其反应机制如下图所示
了Feulgen反应的专一性。2.实验用品材料:(1).Carnoy液固定的鼠肝石蜡切片(2).Carnoy液固定的洋葱根尖或蚕豆根尖切片。试剂:(1).Carnoy固定液:3份95%酒精加入1份冰醋酸。(2).1 mol/L HCl:取比重1.18的浓HCl 82.5ml,加水至100ml。(3).Schiff试剂先将200ml蒸馏水煮沸,由火上取下,加入碱性品红1g,充分搅拌,有助于溶解。待先将200ml蒸馏水煮沸,由火上取下,加入碱性品红1g,充分搅拌,有助于溶解。待亚硫酸钾或偏亚硫酸钠充分振荡后盖紧
 技术资料
技术资料暂无技术资料 索取技术资料